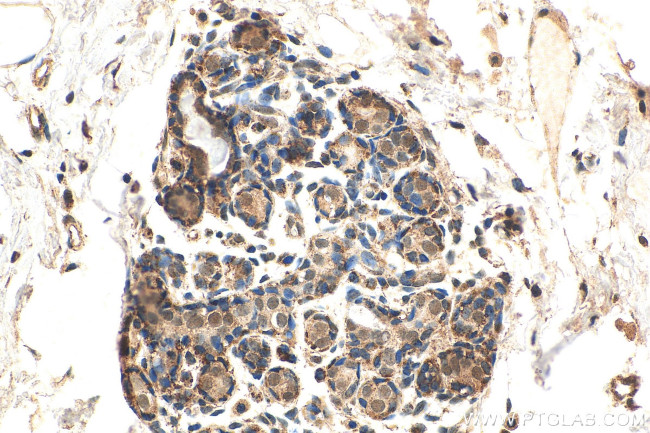
GATA1 Antibody in Immunohistochemistry (Paraffin) (IHC (P))

Search
Proteintech
GATA1 Monoclonal Antibody (5E2A8)
{{$productOrderCtrl.translations['antibody.pdp.commerceCard.promotion.promotions']}}
{{$productOrderCtrl.translations['antibody.pdp.commerceCard.promotion.viewpromo']}}
{{$productOrderCtrl.translations['antibody.pdp.commerceCard.promotion.promocode']}}: {{promo.promoCode}} {{promo.promoTitle}} {{promo.promoDescription}}. {{$productOrderCtrl.translations['antibody.pdp.commerceCard.promotion.learnmore']}}
产品信息
60011-1-IG
种属反应
已发表种属
宿主/亚型
分类
类型
克隆号
抗原
偶联物
形式
浓度
规格
纯化类型
保存液
内含物
保存条件
运输条件
产品详细信息
Immunogen sequence: MEFPGLGSL GTSEPLPQFV DPALVSSTPE SGVFFPSGPE GLDAAASSTA PSTATAAAAA LAYYRDAEAY RHSPVFQVYP LLNCMEGIPG GSPYAGWAYG KTGLYPASTV CPTREDSPPQ AVEDLDGKGS TSFLETLKTE RLSPDLLTLG PALPSSLPVP NSAYGGPDFS STFFSPTGSP LNSAAYSSPK LRGTLPLPPC EARECVNCGA TATPLWRRDR TGHYLCNACG LYHKMNGQNR PLIRPKKRLI VSKRAGTQCT NCQTTTTTLW RRNASGDPVC NACGLYYKLH HQHYCGGSAQ LMRAQSMASR GGVVSFS (1-316 aa encoded by BC009797)
靶标信息
Transcriptional activator or repressor which probably serves as a general switch factor for erythroid development. It binds to DNA sites with the consensus sequence 5'-[AT]GATA[AG]-3' within regulatory regions of globin genes and of other genes expressed in erythroid cells.
仅用于科研。不用于诊断过程。未经明确授权不得转售。
生物信息学
蛋白别名: Eryf1; erythroid DNA-binding protein; Erythroid transcription factor; erythroid transcription factor 1; GATA 1 protein; GATA-1; GATA-binding factor 1; GATA-binding protein 1; GATA-binding protein 1 (globin transcription factor 1); GF-1; globin transcription factor 1; HGNC:4170; NF-E1 DNA-binding protein; nuclear factor, erythroid 1; transcription factor GATA1; unnamed protein product
基因别名: CNSHA9; ERYF1; GATA-1; GATA1; GF-1; GF1; HAEADA; NF-E1; NFE1; XLANP; XLTDA; XLTT
UniProt ID: (Human) P15976, (Mouse) P17679, (Rat) P43429
Entrez Gene ID: (Pig) 100620659, (Human) 2623, (Mouse) 14460, (Rat) 25172